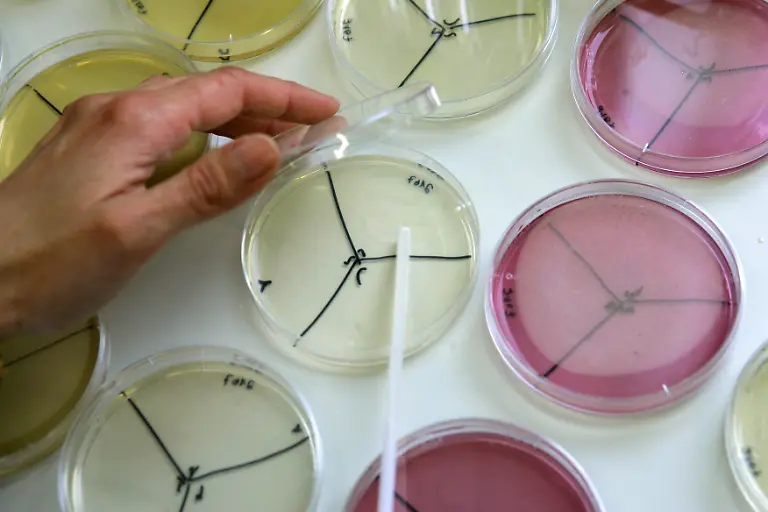
8897757

Bilderserien

"Für den Verbraucher besteht keine akute Gefahr"Dreck im Essen
11.06.2011, 08:08 Uhr
Wenn Dreck in Lebensmitteln landet, ist nicht selten schnöde Profitgier der Grund. Das kann - wie bei Glykol und Gammelfleisch - illegal sein. Es kann jedoch auch an den ganz normalen Produktionsbedingungen der globalisierten Lebensmittelindustrie liegen.